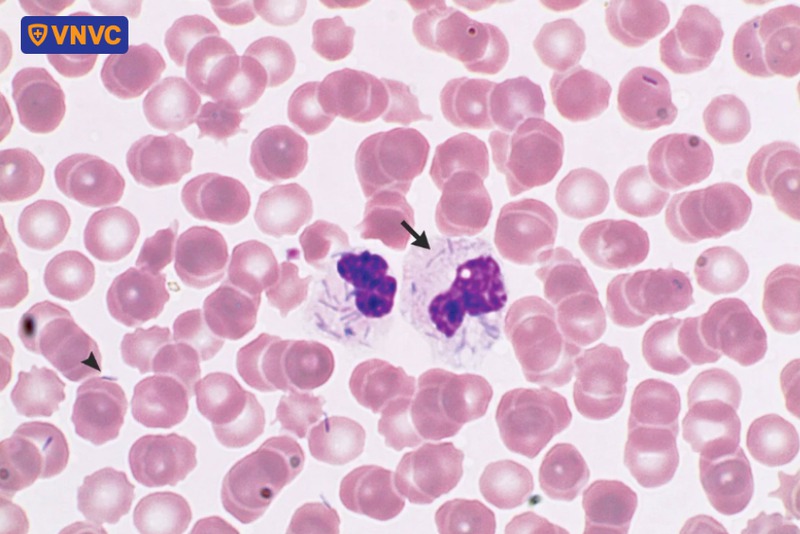
vi khuẩn Capnocytophaga

Bị móng chân chó cào có sao không? Không chảy máu có bị dại?

15:46 04/06/2025

Quản lý Y khoa
Hệ thống Tiêm chủng VNVC
Móng chân chó cào có sao không là thắc mắc thường gặp khi một người vô tình bị chó cào trầy xước da. Dù vết thương có thể nhỏ và không chảy máu, song nguy cơ tiềm ẩn không nên xem nhẹ, đặc biệt nếu chó chưa được tiêm ngừa bệnh dại hoặc có dấu hiệu bất thường về sức khỏe. Việc hiểu rõ mức độ nguy hiểm và thực hiện các bước xử trí phù hợp ngay từ đầu là yếu tố quyết định trong việc bảo vệ sức khỏe, thậm chí là tính mạng của người bệnh.
| ThS.BS Ngô Thị Kim Phượng - Quản lý Y khoa vùng khu vực 2 miền Trung - Tây Nguyên, Hệ thống Trung tâm tiêm chủng VNVC chia sẻ: “Theo Hiệp hội Y khoa Thú y Hoa Kỳ (AVMA), mỗi năm tại Hoa Kỳ có khoảng 4,5 triệu trường hợp bị chó cắn, trong đó gần 800.000 người cần được chăm sóc y tế. Trẻ em là đối tượng dễ bị tổn thương nhất, ngay cả khi tiếp xúc với những con chó quen thuộc. Ngoài ra, có khoảng 400.000 ca bị mèo cắn mỗi năm, dù chưa có thống kê cụ thể về các vết thương do các loài vật nuôi khác gây ra. Dù là chó, mèo hay bất kỳ loài động vật nào, các vết cắn hoặc cào đều tiềm ẩn nguy cơ nhiễm trùng nghiêm trọng, thậm chí dẫn đến nhiễm trùng huyết nếu không được xử lý và theo dõi đúng cách”. |

Bị móng chân chó cào có sao không?
Bị móng chân chó cào có thể dẫn đến nhiều hậu quả nghiêm trọng như nhiễm vi khuẩn Capnocytophaga, nguy cơ mắc bệnh uốn ván, nhiễm trùng huyết và đặc biệt là bệnh dại. Dù vết thương có thể nhỏ, không chảy máu hoặc không gây đau nhiều, song nếu không được xử lý đúng cách và kịp thời, người bị cào vẫn có thể đối mặt với những biến chứng nguy hiểm, thậm chí đe dọa tính mạng.
1. Nhiễm vi khuẩn Capnocytophaga
Theo CDC, Capnocytophaga (1) là nhóm vi khuẩn sống trong khoang miệng của chó và mèo, có thể truyền sang người thông qua vết cắn, cào hoặc liếm vào vùng da bị tổn thương. Dù hiếm gặp, nhưng một khi đã xâm nhập vào máu, vi khuẩn này có thể gây nhiễm trùng huyết nặng, suy đa cơ quan, thậm chí dẫn đến tử vong trong vòng 24 – 72 giờ sau tiếp xúc. (2)
Đặc biệt, người có hệ miễn dịch suy giảm, mắc bệnh nền (đái tháo đường, ung thư, cắt lách…) có nguy cơ cao diễn tiến nặng. Điều quan trọng là phải theo dõi sát tình trạng sau vết thương, đặc biệt nếu xuất hiện sốt, mệt mỏi, đau nhức lan rộng, tụt huyết áp… thì cần đi khám ngay lập tức.
2. Nguy cơ mắc bệnh uốn ván
Uốn ván là bệnh nhiễm trùng cấp tính do vi khuẩn Clostridium tetani gây ra, thường xâm nhập vào cơ thể qua các vết thương hở, bao gồm cả vết trầy xước do móng chân chó. Vi khuẩn tiết ra độc tố thần kinh cực mạnh, gây co cứng cơ, đau nhức toàn thân và có thể dẫn đến tử vong nếu không được điều trị kịp thời.
Tỷ lệ tử vong ở uốn ván cao, đặc biệt ở người chưa từng được tiêm hoặc không còn miễn dịch đầy đủ. Vì vậy, trong mọi trường hợp bị chó cào gây tổn thương da, người bệnh cần đến ngay các cơ sở y tế hoặc bệnh viện gần nhất để đánh thăm khám, bác sĩ sẽ xem xét lịch sử tiêm chủng uốn ván và tiêm phòng nhắc lại nếu cần thiết.
3. Nhiễm trùng huyết
Ngay cả khi chó hoàn toàn khỏe mạnh, móng chân của chúng vẫn có thể mang theo nhiều loại vi khuẩn từ môi trường hoặc do hành vi liếm móng. Khi da người bị trầy xước, các vi khuẩn này dễ dàng xâm nhập vào mô mềm, thậm chí đi vào máu, gây nhiễm trùng tại chỗ và có thể tiến triển nhanh chóng thành nhiễm trùng huyết, một tình trạng cấp cứu đe dọa tính mạng.
Triệu chứng ban đầu có thể chỉ là sưng, đỏ, nóng, đau tại vị trí vết thương. Tuy nhiên, ở một số trường hợp, diễn tiến có thể rất nhanh với các dấu hiệu như sốt cao, mạch nhanh, huyết áp tụt, rối loạn ý thức. Nếu không được xử trí kịp thời, nhiễm trùng huyết có thể dẫn đến suy đa cơ quan và tử vong chỉ sau vài chục giờ.
4. Nguy cơ mắc bệnh dại
Dại là bệnh truyền nhiễm nguy hiểm nhất liên quan đến chó, với tỷ lệ tử vong gần như 100% khi đã xuất hiện triệu chứng. Virus dại tồn tại trong nước bọt của chó mang mầm bệnh và có thể xâm nhập vào cơ thể người qua vết cắn, vết cào hoặc khi chó liếm vào vùng da bị trầy xước.
Đáng lưu ý, ngay cả khi chó chưa có biểu hiện dại rõ ràng, nhưng nếu không rõ nguồn gốc, chưa được tiêm phòng đầy đủ hoặc có hành vi bất thường, mọi vết cào đều cần được xem là nguy cơ. Xử trí đúng cách: rửa kỹ vết thương bằng xà phòng dưới vòi nước chảy, sát trùng và đến cơ sở y tế hoặc bệnh viện gần nhất để được thăm khám, đánh giá nguy cơ và tiêm phòng kịp thời theo phác đồ chống dại, hạn chế tối đa các rủi ro nguy hiểm có thể xảy ra.

Chó cào không chảy máu có sao không?
Chó cào, dù không gây chảy máu, vẫn tiềm ẩn nhiều nguy cơ nghiêm trọng đối với sức khỏe, đặc biệt khi vết thương bị xem nhẹ và không được xử lý đúng cách. Khi móng chó tiếp xúc với da, kể cả chỉ gây trầy xước rất nhẹ, các vi sinh vật gây bệnh có thể xâm nhập qua những vết nứt li ti trên biểu bì (mắt thường thường khó quan sát) nhưng đủ để phá vỡ hàng rào bảo vệ tự nhiên của cơ thể.
Một trong những nguy cơ cần đặc biệt lưu ý là bệnh dại. Đây là căn bệnh truyền nhiễm gần như luôn gây tử vong nếu không được xử lý kịp thời. Virus dại tồn tại trong nước bọt của chó mắc bệnh và có thể truyền sang người không chỉ qua vết cắn sâu mà cả qua vết cào, nếu vùng da bị trầy xước đã từng tiếp xúc với nước bọt.
Nguy hiểm hơn, chó mang virus dại có thể chưa có biểu hiện rõ ràng, nhưng vẫn có khả năng truyền bệnh trong giai đoạn ủ bệnh. Do đó, mọi vết cào do chó không rõ nguồn gốc hoặc chưa tiêm phòng đầy đủ đều cần được xử trí theo phác đồ phòng chống bệnh dại.
⇒ Tham khảo thêm: Dấu hiệu chó bị dại: Làm sao phân biệt với các bệnh khác
Ngoài ra, các vi khuẩn như Capnocytophaga, Staphylococcus aureus, Staphylococcus felis, Staphylococcus simulans... thường cư trú trên da, móng và trong khoang miệng của chó có thể xâm nhập qua vết xước và gây nhiễm trùng tại chỗ, thậm chí lan rộng vào máu. Một số trường hợp diễn tiến nhanh thành nhiễm trùng huyết, hoại tử chi hoặc suy đa cơ quan, đặc biệt ở người có cơ địa suy giảm miễn dịch. (3)
Vì vậy, bị chó cào dù chỉ trầy xước, vết thương không chảy máu cũng không được xem nhẹ. Người bệnh cần xử lý vết thương ngay, theo dõi tình trạng con vật, và chủ động đến cơ sở y tế hoặc bệnh viện gần nhất để được đánh giá nguy cơ, đảm bảo tính mạng.
Cách xử lý khi bị móng chân chó cào
1. Sơ cứu tại nhà
Khi bị móng chân chó cào, việc sơ cứu đúng cách ngay từ đầu là yếu tố then chốt để giảm thiểu nguy cơ nhiễm trùng và các biến chứng nghiêm trọng. Dù vết cào có thể chỉ là trầy xước nhẹ, không chảy máu, nhưng vẫn cần xử lý một cách thận trọng.
Trước tiên, rửa sạch vùng da bị thương dưới vòi nước sạch chảy liên tục trong ít nhất 15 phút để loại bỏ bụi bẩn, vi khuẩn và virus có thể xâm nhập. Sau đó, dùng cồn 45 – 70 độ hoặc cồn i-ốt để sát khuẩn vết thương.
Vết cào nên được để hở, không băng kín trừ khi có chỉ định của bác sĩ hoặc vết thương lớn, chảy máu nhiều. Sau sơ cứu, theo dõi kỹ các dấu hiệu bất thường tại chỗ như sưng đỏ, mưng mủ, đau nhức hoặc sốt toàn thân.

2. Khi nào cần gặp bác sĩ?
Móng chân chó cào có sao không? Trường hợp nào cần đến gặp bác sĩ cũng là thắc mắc được nhiều người quan tâm. Chuyên gia khuyến cáo, người bệnh nên đến cơ sở y tế nếu rơi vào một trong các tình huống sau:
- Vết thương nằm ở vùng mặt, cổ, tay, chân hoặc gần các khớp
- Máu không ngừng chảy sau 10 phút dù đã ấn trực tiếp để cầm máu
- Vết thương có kích thước lớn, sâu hoặc có dấu hiệu nghiêm trọng
- Con vật gây ra vết thương là động vật hoang dã, đi lạc hoặc có hành vi bất thường
- Vết thương có mủ, trở nên đỏ, nóng, sưng tấy hoặc đau nhiều hơn theo thời gian
- Người bị thương có hệ miễn dịch yếu hoặc mắc bệnh lý làm tăng nguy cơ nhiễm trùng
- Người bị thương chưa được tiêm phòng uốn ván đầy đủ (4)
Việc đến cơ sở y tế kịp thời giúp bác sĩ đánh giá chính xác nguy cơ, chỉ định tiêm vắc xin phòng dại, vắc xin uốn ván nếu cần thiết và theo dõi sát các dấu hiệu nhiễm trùng, hạn chế tối đa các biến chứng nguy hiểm ảnh hưởng đến tính mạng người bệnh.
3. Tiêm vắc xin ngừa dại
Hiện nay, vắc xin và huyết thanh kháng dại là biện pháp điều trị dự phòng duy nhất để phòng bệnh dại. Các bác sĩ khuyến cáo người dân, ngay sau khi bị động vật cắn hoặc cào, hãy nhanh chóng đến cơ sở y tế để tiêm ngừa và xử trí vết thương. Đáng lưu ý, không có giới hạn thời gian tối đa để tiêm vắc xin phòng dại sau khi phơi nhiễm, do đó ngay cả khi đã muộn, mọi người vẫn nên đến cơ sở y tế để được tư vấn và tiêm phòng.
Lịch tiêm vắc xin phòng dại thường gồm 5 mũi trong vòng một tháng vào các ngày N0 - N3 - N7 - N14 - N28. Việc tiếp tục hay dừng liệu trình tiêm phụ thuộc vào mức độ vết thương cũng như kết quả theo dõi con vật trong 10 ngày sau khi cắn.
Ngoài ra, để chủ động phòng bệnh và giảm thiểu rủi ro, những người thường xuyên tiếp xúc với động vật như chó, mèo được khuyến nghị tiêm dự phòng bệnh dại. Phác đồ tiêm dự phòng bao gồm 3 mũi cơ bản vào các ngày N0 - N7 - N21 (hoặc ngày 28). Trong trường hợp bị cào, cắn sau khi đã tiêm dự phòng, người dân chỉ cần tiêm bổ sung 2 mũi mà không cần sử dụng thêm huyết thanh kháng dại, kể cả với vết thương nghiêm trọng.

Làm gì để ngăn chó không cào người?
Việc phòng tránh nguy cơ bị chó cào không chỉ giúp bảo vệ sức khỏe cho con người mà còn góp phần xây dựng môi trường sống an toàn, thân thiện giữa người và vật nuôi. Để hạn chế tối đa những tình huống không mong muốn, cần áp dụng đồng thời nhiều biện pháp quản lý hành vi và chăm sóc vật nuôi đúng cách.
1. Dạy chó kiểm soát hành vi
Huấn luyện chó kiểm soát hành vi là nền tảng quan trọng để ngăn ngừa tình trạng cào người. Việc dạy chó các lệnh cơ bản như “ngồi”, “ở yên”, “không” hay “thả ra” cần được bắt đầu từ sớm, tốt nhất là khi chó còn nhỏ.
Trong quá trình huấn luyện, nên sử dụng phương pháp củng cố tích cực, tức là khen thưởng ngay khi chó có phản ứng đúng. Tránh la mắng hoặc dùng bạo lực vì có thể khiến chó sợ hãi hoặc trở nên hung dữ hơn. Với những con chó có hành vi bất ổn, nên tham khảo ý kiến của bác sĩ thú y hoặc chuyên gia hành vi động vật để có biện pháp can thiệp phù hợp.
2. Cắt móng chân định kỳ cho chó
Móng chân dài là yếu tố trực tiếp gây trầy xước khi chó cào người. Việc cắt móng chân định kỳ giúp giảm nguy cơ này và hạn chế tổn thương khi chó vô tình hoặc cố ý dùng chân tiếp xúc với người. Ngoài ra, móng dài còn có thể gây đau đớn hoặc biến dạng khớp chân ở chó. Khi cắt móng, cần chú ý không cắt quá sâu vào phần tủy móng để tránh chảy máu và đau đớn cho vật nuôi. Nếu không có kinh nghiệm, nên đưa chó đến cơ sở thú y hoặc cửa hàng chăm sóc thú cưng để được cắt móng an toàn.

3. Sử dụng giày, bao chân cho chó
Trong một số tình huống như khi đưa chó ra nơi công cộng hoặc tiếp xúc với người già, trẻ nhỏ, việc sử dụng giày hoặc bao chân cho chó là một giải pháp hữu hiệu. Loại phụ kiện này không chỉ giúp giảm nguy cơ gây trầy xước mà còn hạn chế việc mang bụi bẩn, vi khuẩn từ ngoài vào nhà. Tuy nhiên, cần chọn loại giày phù hợp với kích thước và dáng chân của chó để không gây khó chịu khi di chuyển. Ngoài ra, nên tập cho chó làm quen dần để tránh phản ứng tiêu cực.
Móng chân chó cào có sao không phụ thuộc rất lớn vào tình trạng sức khỏe của con vật, mức độ tổn thương da và cách xử trí ban đầu. Dù vết thương có vẻ nhẹ, người bị cào vẫn cần thận trọng, theo dõi dấu hiệu nhiễm trùng và chủ động đến cơ sở y tế để được tư vấn, đánh giá nguy cơ, tiêm phòng nếu cần thiết. Chủ động bảo vệ sức khỏe ngay từ những vết trầy nhỏ là cách tốt nhất để phòng tránh những biến chứng nguy hiểm, đặc biệt là bệnh dại, căn bệnh vẫn chưa có thuốc điều trị đặc hiệu với tỷ lệ tử vong 100% khi phát bệnh.
- CDC. (2024, June 21). About Capnocytophaga. Centers for Disease Control and Prevention. https://www.cdc.gov/capnocytophaga/about/index.html
- Q&A: Bacteria in dog and cat saliva can make humans sick. (2018, August 17). Healio.com. https://www.healio.com/news/infectious-disease/20180816/qa-bacteria-in-dog-and-cat-saliva-can-makes-humans-sick
- Fábio V R Portilho, Juliano Nóbrega, Beatriz, Bello, T. S., Paz, P. J. L., Oliveira, A. L., Bosco, S. M. G., Rall, V. L. M., Giuffrida, R., & Ribeiro, M. G. (2024). The polymicrobial nature of the oral cavity and claws of cats diagnosed by mass spectrometry and next-generation sequencing. ScienceDirect.com. https://www.sciencedirect.com/science/article/abs/pii/S0882401024002328
- Animal Bites and Scratches (for Parents). (2023). Kidshealth.org. https://kidshealth.org/en/parents/bites.html







